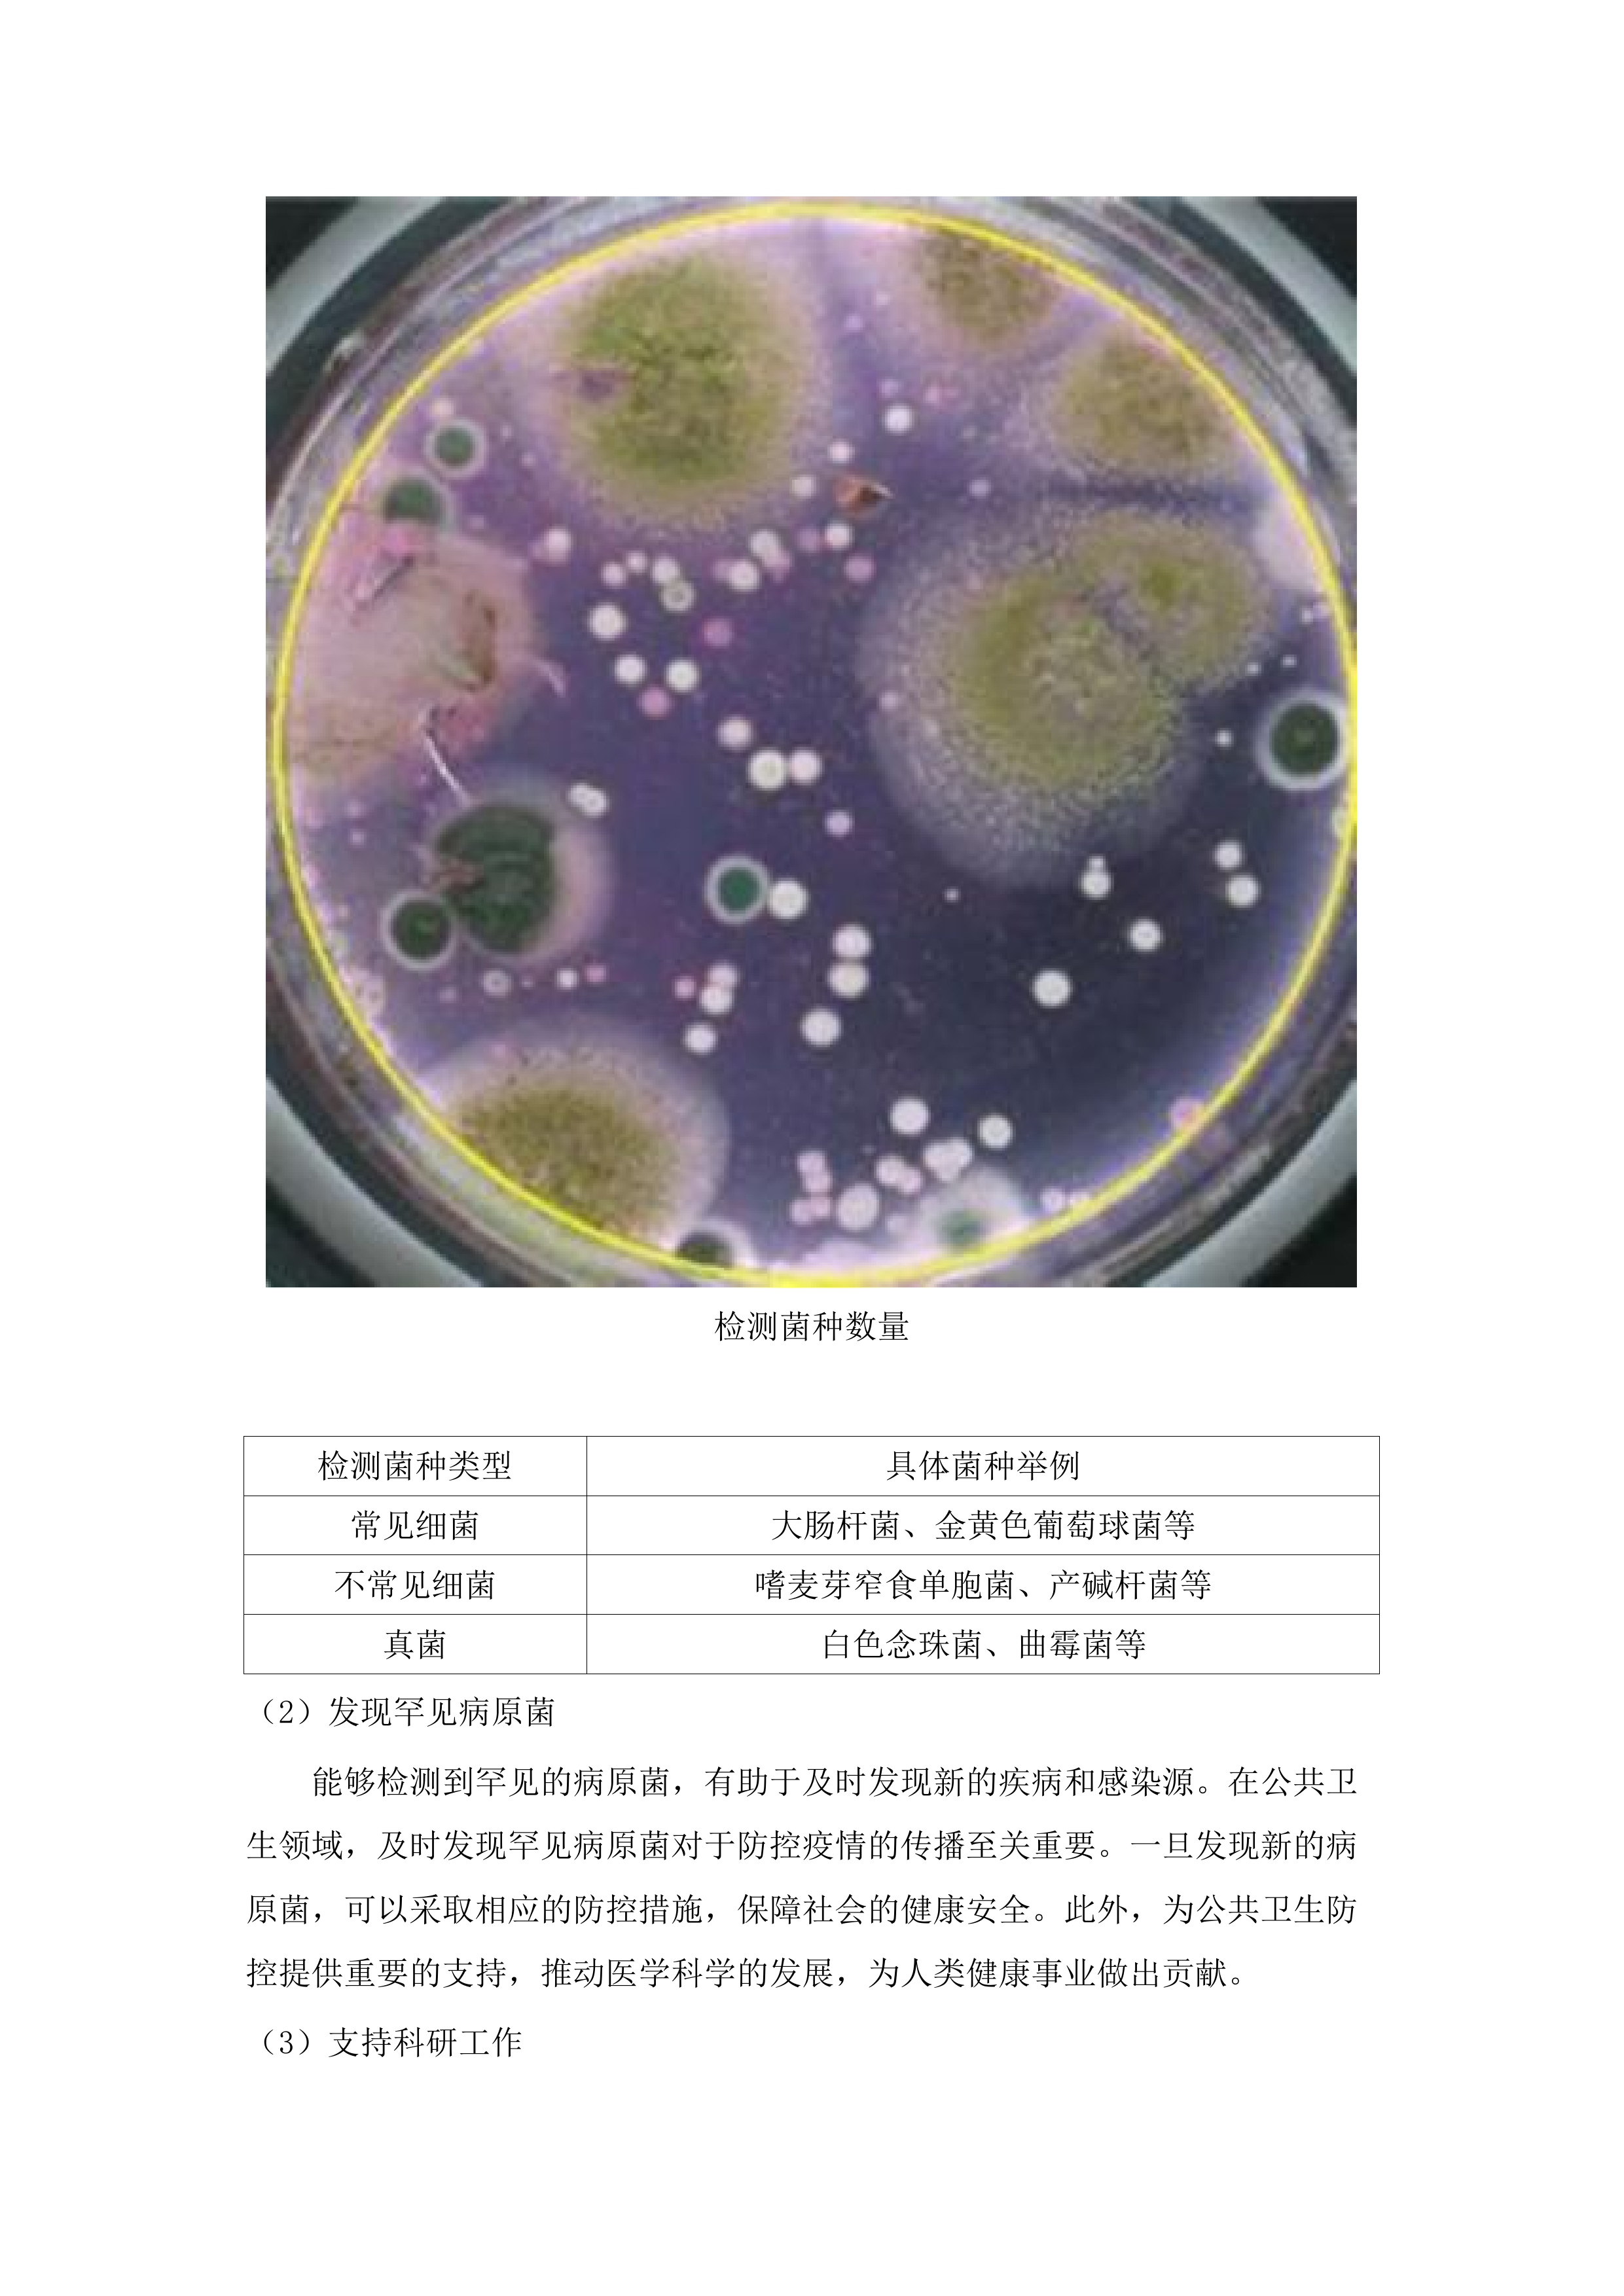
提升分级诊疗能力建设项目第一批.docx 第10页

提升分级诊疗能力建设项目第一批
第一章 技术参数
8
第一节 技术参数响应
8
一、 全自动细菌鉴定药敏分析仪参数
8
二、 胰岛素泵技术参数响应
13
三、 眼底照相机参数响应
24
四、 动态心电记录仪参数
38
五、 压缩式雾化器参数响应
58
第二节 技术支持资料
69
一、 细菌鉴定药敏分析仪资料
69
二、 胰岛素泵技术支持材料
76
三、 眼底照相机支持资料
87
四、 动态心电记录仪资料
98
五、 压缩式雾化器技术资料
110
第三节 设备功能与参数对照
117
一、 细菌鉴定药敏分析仪对照
117
二、 胰岛素泵参数条款对照
130
三、 眼底照相机参数对照
141
四、 动态心电记录仪对照
156
五、 压缩式雾化器参数对照
172
第四节 设备使用科室匹配
182
一、 检验科设备匹配分析
182
二、 内分泌科设备匹配情况
192
三、 肺病科设备匹配分析
206
四、 电诊科设备匹配情况
212
第五节 设备兼容性与扩展性
227
一、 细菌鉴定药敏分析仪对接
228
二、 动态心电记录仪扩展性
240
第二章 供货实施及运输方案
262
第一节 供货期限安排
262
一、 明确总工期目标
262
二、 按设备定供货节点
273
三、 制定详细供货计划
289
四、 明确特殊设备到货期
311
第二节 运输组织措施
322
一、 制定分类运输方案
322
二、 选用专业物流公司
335
三、 设备独立包装标识
341
四、 实时监控运输车辆
353
五、 制定运输应急预案
365
第三节 供货进度保障
385
一、 建立进度管理小组
385
二、 设立本地仓储中转
393
三、 与采购单位常沟通
408
四、 提供进度可视化报表
422
第四节 运输方案可行性
430
一、 实地踏勘运输路线
430
二、 评估运输车辆适配
443
三、 制定运输作业流程
458
四、 提供运输过程记录
468
第三章 设备安装调试方案
490
第一节 安装调试理解
490
一、 全自动细菌鉴定及药敏试验分析仪
490
二、 胰岛素泵
498
三、 眼底照相机
509
四、 动态心电记录仪
518
五、 压缩式雾化器
531
第二节 安装流程规划
542
一、 动态心电记录仪
542
二、 压缩式雾化器
548
三、 全自动细菌鉴定及药敏试验分析仪
560
四、 胰岛素泵
567
五、 眼底照相机
577
第三节 调试措施说明
582
一、 通电测试
582
二、 接口测试
592
三、 模拟使用测试
603
四、 UPS电源测试
613
第四节 现场实施安排
622
一、 沟通安装时间
622
二、 派驻专业团队
635
三、 出具调试报告
643
四、 控制安装周期
651
第五节 质量保障措施
665
一、 人员资质保障
665
二、 配件质量保障
682
三、 参数验证保障
691
四、 过程记录保障
703
第四章 培训方案
710
第一节 培训内容计划
710
一、 全自动细菌鉴定及药敏试验分析仪培训
710
二、 胰岛素泵培训
712
三、 眼底照相机培训
717
四、 动态心电记录仪培训
721
五、 压缩式雾化器培训
724
第二节 培训对象安排
728
一、 检验科人员培训
728
二、 内分泌代谢病科人员培训
733
三、 肺病科人员培训
738
四、 电诊科人员培训
742
第三节 培训时间与频次
746
一、 全自动细菌鉴定及药敏试验分析仪培训时间
747
二、 胰岛素泵培训时间
752
三、 眼底照相机培训时间
755
四、 动态心电记录仪培训时间
760
五、 压缩式雾化器培训时间
766
第四节 培训方式与地点
772
一、 现场实操培训
772
二、 理论讲解培训
781
三、 检验科培训地点
789
四、 内分泌代谢病科培训地点
796
五、 肺病科培训地点
801
六、 电诊科培训地点
806
第五节 培训人数与组织
813
一、 全自动细菌鉴定及药敏试验分析仪培训人数
813
二、 胰岛素泵培训人数
821
三、 眼底照相机培训人数
831
四、 动态心电记录仪培训人数
838
五、 压缩式雾化器培训人数
842
六、 培训组织工作
850
第六节 培训结果评估
857
一、 现场操作演示评估
857
二、 问答测试评估
864
三、 培训记录表生成
870
四、 参训人员签字确认
875
五、 提交采购人备案
879
第五章 应急方案
886
第一节 突发事件应对
886
一、 供货环节突发情况应对
886
二、 安装调试突发情况处理
893
三、 培训环节突发状况预案
900
四、 现场安全事件应急处置
909
第二节 应急响应机制
919
一、 应急响应组织架构
919
二、 24小时值班制度
928
三、 与采购人联络机制
937
四、 应急物资储备设置
945
第三节 应急演练与评估
953
一、 项目实施前应急演练
953
二、 演练后评估报告
964
三、 项目执行中复盘机制
970
四、 突发事件处置记录
977
第六章 售后服务
987
第一节 售后保障措施
987
一、 全自动细菌鉴定药敏仪保修
987
二、 胰岛素泵售后保障
1000
三、 眼底照相机售后安排
1010
四、 动态心电记录仪售后
1028
五、 压缩式雾化器售后
1045
第二节 维修响应解决时间
1054
一、 全自动细菌鉴定药敏仪响应
1054
二、 胰岛素泵维修时间
1071
三、 眼底照相机维修安排
1081
四、 动态心电记录仪维修
1092
五、 压缩式雾化器维修
1098
第三节 故障处理办法
1106
一、 全自动细菌鉴定药敏仪故障
1106
二、 胰岛素泵故障处理
1115
三、 眼底照相机故障解决
1126
四、 动态心电记录仪故障
1139
五、 压缩式雾化器故障
1148
技术参数
技术参数响应
全自动细菌鉴定药敏分析仪参数
鉴定及药敏分析功能响应
细菌真菌鉴定响应
多方法鉴定优势
多波长比色和比浊方法结合,能从多个维度对细菌和真菌进行检测,显著提高鉴定的准确性和可靠性。不同的检测方法可以捕捉到细菌和真菌的多种特征,从而更精确地确定细菌种类,为临床诊断提供更精准的信息。在实际应用中,能够有效识别不同细菌的特征,减少误诊和漏诊的可能性,为患者的治疗提供坚实的基础。此外,这种多方法结合的检测方式还能适应不同类型的样本和检测需求,提高了设备的通用性和适用性。
鉴定及药敏分析
常见菌检测能力
对于临床常见的细菌,能够快速准确地进行鉴定和药敏分析,为临床治疗提供及时的支持。可以有效检测常见菌的耐药性,指导合理使用抗菌药物,避免因滥用抗生素导致的耐药问题。在实际临床工作中,能够提高对常见菌感染的诊断效率,缩短治疗周期,减轻患者的痛苦和经济负担。同时,还能为医院的感染防控工作提供重要的依据,减少医院感染的发生。
常见菌检测
不常见菌检测
不常见菌检测优势
针对不常见菌也具备良好的检测能力,能够发现罕见的细菌感染,为疑难病症的诊断提供帮助。在临床实践中,有些不常见菌感染的症状可能不典型,容易被误诊或漏诊。而该设备能够准确检测出这些不常见菌,为患者的治疗提供正确的方向。此外,有助于及时发现新的病原菌,为公共卫生防控提供支持,保障社会的健康安全。还能为临床研究提供更多的细菌样本和数据,推动医学科学的发展。
检测菌种数量参数响应
菌种数量达标响应
满足检测需求
可对多种常见和不常见的细菌及真菌进行检测,为临床诊断提供全面的信息。能够适应不同患者的病情和临床需求,提高诊断的准确性和可靠性。在实际应用中,不同患者的感染情况可能不同,有些患者可能感染的是常见菌,而有些患者可能感染的是不常见菌。该设备能够检测多种类型的细菌和真菌,为临床治疗提供更精准的用药指导,提高治疗效果。以下是检测菌种的部分类型表格:
检测菌种数量
检测菌种类型
具体菌种举例
常见细菌
大肠杆菌、金黄色葡萄球菌等
不常见细菌
嗜麦芽窄食单胞菌、产碱杆菌等
真菌
白色念珠菌、曲霉菌等
发现罕见病原菌
能够检测到罕见的病原菌,有助于及时发现新的疾病和感染源。在公共卫生领域,及时发现罕见病原菌对于防控疫情的传播至关重要。一旦发现新的病原菌,可以采取相应的防控措施,保障社会的健康安全。此外,为公共卫生防控提供重要的支持,推动医学科学的发展,为人类健康事业做出贡献。
支持科研工作
丰富的菌种样本资源为医院的科研工作提供了有力的支持。科研人员可以利用这些样本进行深入的研究,探索细菌和真菌的生物学特性、致病机制等。通过科研工作的开展,能够促进医学科研的创新和发展,提高医院的学术水平和影响力。以下是科研工作受益的部分方面表格:
科研工作受益方面
具体说明
疾病机制研究
研究细菌和真菌的致病机制
药物研发
筛选有效的抗菌药物
流行病学研究
了解病原菌的传播规律
配套试剂种类参数响应
试剂种类丰富响应
覆盖多种微生物
配套试剂可针对革兰阳性球菌、革兰阳性杆菌、革兰阴性菌和真菌等进行检测,全面覆盖了常见的微生物类型。为临床诊断提供了更广泛的检测范围,提高了诊断的准确性和可靠性。在实际临床工作中,不同类型的微生物感染需要使用不同的检测方法和试剂。该设备的配套试剂能够覆盖多种微生物类型,有助于发现不同类型的感染,为临床治疗提供更精准的用药指导。以下是覆盖微生物类型及检测意义表格:
微生物类型
检测意义
革兰阳性球菌
常见的病原菌,检测有助于针对性治疗
革兰阳性杆菌
部分为条件致病菌,检测可判断感染情况
革兰阴性菌
一些具有较强的耐药性,检测指导用药
真菌
近年来感染率上升,检测利于治疗
满足多样需求
丰富的试剂种类能够满足不同检测项目的需求,适应检验科的多样化工作。在检验科,每天需要进行大量的检测项目,不同的检测项目可能需要使用不同的试剂。该设备的配套试剂种类丰富,能够满足这些多样化的需求,提高了设备的使用效率,减少了因试剂不足导致的检测延误。为临床诊断和治疗提供了及时的支持,保障了患者的健康权益。
适应不同场景
可在不同的临床检测场景中使用,如门诊、病房、手术室等。在不同的场景中,对检测设备和试剂的要求可能不同。该设备的配套试剂具有良好的适应性,能够在各种场景下正常使用,提高了设备的适用性和灵活性,为医院的临床工作提供了便利。有助于提高医院的医疗服务质量和效率。以下是不同场景下试剂使用优势表格:
临床检测场景
试剂使用优势
门诊
快速检测,及时提供结果
病房
方便床旁检测,满足患者需求
手术室
可在紧急情况下快速检测
软件系统功能参数响应
全中文界面响应
方便操作使用
全中文界面直观易懂,操作人员无需具备专业的外语知识即可轻松操作。对于一些基层医院或非专业人员来说,全中文界面降低了操作门槛,提高了设备的普及性和易用性。能够让更多的人快速掌握设备的使用方法,有助于提高检验科的工作效率,减少因操作不熟练导致的错误。以下是全中文界面优势体现表格:
优势体现方面
具体说明
操作便捷性
无需外语基础,快速上手
降低错误率
减少因语言理解困难导致的操作失误
提高工作效率
节省学习和操作时间
减少操作失误
避免了因语言理解困难导致的操作失误,提高了检测结果的准确性和可靠性。在检测过程中,一个小小的操作失误可能会导致检测结果的偏差,从而影响临床诊断和治疗。全中文界面能够让操作人员更准确地理解操作指令,降低了医疗风险,保障了患者的健康权益。提高了医院的医疗质量和安全水平。
提高设备利用率
操作人员能够更快速地掌握软件的使用方法,提高了设备的使用效率。由于全中文界面易于理解,操作人员可以在短时间内熟悉软件的各项功能,减少了设备的闲置时间,提高了医院的资源利用效率。为医院的经济效益和社会效益做出了贡献。
生物安全标准参数响应
气溶胶泄露防护响应
符合安全标准
严格按照微生物实验室生物安全的最高危害评估标准进行设计和制造,确保设备的安全性。在设计和制造过程中,经过专业的检测和验证,符合相关的安全规范和要求。为操作人员提供了可靠的安全保障,降低了职业暴露的风险。在微生物检测过程中,操作人员可能会接触到各种病原菌,一旦发生气溶胶泄露,就会对操作人员的健康造成威胁。该设备的设计符合安全标准,能够有效避免这种情况的发生。
保护人员安全
防止气溶胶泄露可有效保护操作人员的安全,避免感染病原菌。气溶胶中可能含有各种病原菌,如果泄露到空气中,操作人员吸入后就可能感染疾病。该设备通过有效的防护措施,能够防止气溶胶泄露,减少了因职业暴露导致的疾病传播,保障了操作人员的身体健康。提高了操作人员的工作积极性和安全性,促进了实验室的正常运转。
防止病菌扩散
有效防止病原菌的传播和扩散,保障实验室的生物安全。在实验室中,如果病原菌扩散到周围环境中,可能会引发更广泛的感染。该设备能够防止气溶胶泄露,从而有效防止病原菌的传播和扩散,减少了实验室感染的发生,降低了医院感染的风险。为医院的公共卫生安全提供了有力的支持。
胰岛素泵技术参数响应
基础率及大剂量参数响应
基础率步长响应
响应招标文件要求
响应招标文件要求,胰岛素泵基础率步长≤0.05U/小时,能精准为患者输注微量胰岛素。在临床治疗中,患者的胰岛素需求存在个体差异,此精准步长可根据患者的具体情况,如年龄、体重、病情等,为患者量身定制胰岛素输注方案,满足患者精细化治疗的需求。精准的基础率步长设置,能够避免胰岛素输注过多或过少的情况发生,保障患者的血糖稳定。
项目
详情
基础率步长
≤0.05U/小时
作用
精准输注胰岛素,满足精细化治疗需求
保障治疗精准性
该基础率步长可依据患者的个体差异和实际病情,精确调整胰岛素输注量。不同患者的身体状况和胰岛素敏感性不同,通过精准调整输注量,能使胰岛素的输注与患者的需求相匹配,提高治疗效果。例如,对于胰岛素敏感性较高的患者,可以适当降低基础率步长,减少胰岛素的输注量;而对于胰岛素抵抗较严重的患者,则可以增加基础率步长,确保足够的胰岛素供应。这样能够有效控制患者的血糖水平,减少并发症的发生,保障患者的健康。
项目
详情
调整依据
患者个体差异和实际病情
效果
精确调整输注量,提高治疗效果
符合临床使用标准
此参数设置符合临床治疗对胰岛素输注精准度的要求。在临床实践中,精准的胰岛素输注对于控制患者的血糖水平至关重要。该基础率步长的设置,能够满足医生在制定治疗方案时对胰岛素输注精准度的需求,有助于医生根据患者的具体情况,制定更加科学合理的治疗方案。同时,精准的输注也能够提高患者对治疗的依从性,减少因血糖波动而带来的不适和风险。
项目
详情
符合标准
临床治疗对胰岛素输注精准度的要求
作用
有助于制定科学合理的治疗方案
适应多样化需求
能适应不同患者在不同治疗阶段的多样化需求。患者在治疗过程中,其胰岛素需求会随着病情的变化、饮食、运动等因素而发生改变。该胰岛素泵的基础率步长设置,能够灵活调整胰岛素的输注量,为患者提供个性化的治疗服务。在患者病情稳定期,可以适当降低基础率步长,减少胰岛素的输注量;而在患者病情波动期,则可以增加基础率步长,确保血糖的稳定控制。这种个性化的治疗服务,能够提高患者的治疗效果和生活质量。
基础率时段响应
满足时段设置需求
胰岛素泵基础率时段≤48段,可灵活设置不同时间段的胰岛素输注量。人体的生理活动在一天内具有节律性,血糖水平也会随之波动。通过设置多个基础率时段,能够根据患者在一天内不同时段的生理需求,精准调整胰岛素的输注量。在早餐后,人体血糖会升高,此时可以适当增加胰岛素的输注量;而在夜间睡眠时,人体血糖相对稳定,可以降低胰岛素的输注量。这样能够更好地模拟人体胰腺的分泌节律,满足患者的生理需求。
贴合人体生理节律
这种设置能够更好地模拟人体胰腺的分泌节律,使胰岛素的输注更加符合人体生理规律。人体胰腺在不同时间段会分泌不同量的胰岛素,以维持血糖的稳定。胰岛素泵的基础率时段设置,能够根据人体的生理节律,调整胰岛素的输注量,使患者的血糖水平更加稳定。这种贴合人体生理节律的输注方式,能够提高治疗的有效性,减少并发症的发生。
方便医生调整方案
医生可以根据患者的具体情况,如饮食、运动、血糖波动等,方便地调整基础率时段和输注量。患者的饮食和运动习惯会影响血糖水平,医生可以根据患者的这些情况,调整胰岛素泵的基础率时段和输注量。如果患者在某一天进行了剧烈运动,医生可以适当降低该时段的胰岛素输注量,以避免低血糖的发生。这种方便的调整方式,有助于医生优化治疗方案,提高治疗效果。
项目
详情
调整依据
患者饮食、运动、血糖波动等情况
作用
方便医生优化治疗方案
提高患者治疗依从性
合理的基础率时段设置有助于稳定患者的血糖水平,减少血糖波动。血糖波动会给患者带来不适,如头晕、乏力等,影响患者的生活质量和治疗依从性。通过合理设置基础率时段,使胰岛素的输注更加符合人体生理规律,能够有效稳定患者的血糖水平,减少血糖波动带来的不适。这样患者能够更好地接受治疗,提高治疗的依从性。
项目
详情
设置效果
稳定血糖水平,减少血糖波动
作用
提高患者治疗依从性
大剂量增量响应
实现精确剂量调整
胰岛素泵大剂量增量≤0.1U,能够精确控制大剂量胰岛素的输注。在患者进食后,需要额外的胰岛素来降低血糖。精确的大剂量增量设置,能够根据患者的进食量和血糖水平,精确调整胰岛素的输注量,避免因剂量过大或过小而影响治疗效果。如果剂量过大,可能会导致低血糖的发生;如果剂量过小,则无法有效控制血糖。这种精确的剂量调整,能够保障患者的血糖稳定。
胰岛素泵大剂量增量
应对不同饮食情况
在患者进食不同量的食物时,可根据实际情况精确调整大剂量胰岛素的输注量。不同的食物含有不同的碳水化合物、蛋白质和脂肪,对血糖的影响也不同。该胰岛素泵的大剂量增量设置,能够根据患者的饮食情况,精确调整胰岛素的输注量,更好地控制餐后血糖。如果患者进食了高碳水化合物的食物,需要增加胰岛素的输注量;而如果患者进食了低热量的食物,则可以适当减少胰岛素的输注量。
保障血糖平稳控制
精确的大剂量增量设置有助于维持患者血糖的平稳,减少血糖波动带来的风险。血糖波动会对患者的身体造成损害,增加并发症的发生风险。通过精确调整大剂量胰岛素的输注量,能够使患者的血糖水平更加稳定,减少血糖波动带来的风险。这种平稳的血糖控制,能够提高患者的生活质量,降低并发症的发生率。
符合临床安全标准
该参数设置符合临床治疗对胰岛素输注安全性和精确性的要求。在临床治疗中,胰岛素输注的安全性和精确性至关重要。精确的大剂量增量设置,能够避免因胰岛素输注过多或过少而导致的低血糖或高血糖情况发生,保障患者的治疗安全。符合临床安全标准的参数设置,能够为患者提供可靠的治疗保障。
电池及储药器参数响应
电池类型响应
提供多种电池选择
胰岛素泵电池为锂电池/碱性电池,为用户提供了多种选择。不同的患者有不同的需求和使用场景,锂电池和碱性电池各有优缺点。锂电池具有能量密度高、重量轻等优点,适合长期携带使用;碱性电池则易于购买和更换,在紧急情况下能及时满足患者的使用需求。患者可以根据自己的实际情况,选择合适的电池类型。
胰岛素泵储药器
电池类型
优点
锂电池
能量密度高、重量轻,适合长期携带
碱性电池
易于购买和更换,满足紧急需求
满足不同使用需求
锂电池具有能量密度高、重量轻等优点,适合长期携带使用。对于需要经常外出的患者来说,锂电池的轻便性能够减少负担,方便患者携带胰岛素泵。而碱性电池则易于购买和更换,在紧急情况下能及时满足患者的使用需求。如果患者在外出时锂电池电量耗尽,碱性电池可以作为备用电源,确保胰岛素泵的正常运行。两种电池类型的选择,能够满足不同患者的使用需求。
保障设备持续运行
两种电池类型的选择确保了胰岛素泵在不同环境下都能稳定运行。无论是在日常生活中,还是在旅行、出差等特殊环境下,患者都可以根据实际情况选择合适的电池类型,保障胰岛素泵的持续运行。在一些偏远地区,可能无法及时购买到锂电池,此时碱性电池就可以发挥作用。这种电池类型的选择,为患者的治疗提供了持续保障。
电池类型
适用环境
锂电池
日常使用、长期携带
碱性电池
紧急情况、偏远地区
提高设备适用性
这种设计提高了胰岛素泵的适用性,能够满足不同患者群体的使用习惯和需求。不同年龄、性别、生活方式的患者,对胰岛素泵的使用需求和偏好也不同。一些年轻患者可能更倾向于使用锂电池,因为其轻便性和高科技感;而一些老年患者可能更习惯使用碱性电池,因为其易于购买和更换。胰岛素泵提供多种电池类型选择,能够适应不同患者的使用习惯和需求,提高设备的适用性。
储药器容量响应
满足使用周期需求
胰岛素泵储药器≥300U(3mL),能够满足患者一定时间内的胰岛素使用需求。患者在使用胰岛素泵时,需要定期更换储药器。较大的储药器容量可以减少更换储药器的频率,一般来说,对于大多数患者,一个300U(3mL)的储药器可以使用数天甚至一周,减少了频繁更换储药器的麻烦。这样能够提高患者的使用体验,使患者更加方便地进行治疗。
减少感染风险
减少更换储药器的次数,可降低因操作不当而引起的感染风险。在更换储药器的过程中,如果操作不当,可能会导致细菌感染,影响患者的健康。较大的储药器容量可以减少更换储药器的次数,从而降低感染的风险。每次更换储药器都需要严格遵守无菌操作规范,减少操作次数可以降低因操作失误而导致感染的可能性,保障患者的健康安全。
提高使用便利性
较大的储药器容量提高了胰岛素泵使用的便利性。患者在使用胰岛素泵时,无需频繁关注储药器的剩余药量,也无需频繁更换储药器。这使得患者在使用过程中更加轻松自在,减少了因频繁更换储药器而带来的不便。尤其是对于一些行动不便或视力不好的患者来说,较大的储药器容量更加方便他们使用胰岛素泵。
符合治疗连续性要求
该储药器容量设置符合胰岛素治疗的连续性要求。胰岛素治疗需要持续、稳定地输注胰岛素,以维持血糖的稳定。较大的储药器容量可以确保在一定时间内胰岛素的持续供应,避免因储药器药量不足而中断治疗。这样能够保证患者的血糖水平更加稳定,提高治疗效果,符合胰岛素治疗的连续性要求。
耗材类型响应
适配不同患者需求
胰岛素泵耗材为钢针/软针,可针对不同皮肤和不同需求的患者使用。不同患者的皮肤状况和使用需求不同,一些患者皮肤较为敏感,使用软针可以减少不适感;而一些患者运动较多,钢针则更加牢固,不易脱落。这种多样化的耗材选择,能够提高胰岛素泵的适配性,满足不同患者的需求。
胰岛素泵钢针耗材
胰岛素泵软针耗材
提供个性化治疗方案
对于皮肤敏感的患者,软针可以减少不适感。软针质地柔软,在插入皮肤时对皮肤的刺激较小,能够减轻患者的疼痛和不适感。而对于运动较多的患者,钢针则更加牢固,能够在患者运动过程中保持稳定,确保胰岛素的正常输注。这种个性化的治疗方案,能够提高患者的治疗效果和生活质量。
提高患者舒适度
不同类型的耗材选择能够提高患者在使用胰岛素泵过程中的舒适度。患者在使用胰岛素泵时,舒适度是一个重要的考虑因素。合适的耗材类型可以减少患者的不适感,使患者更加愿意接受治疗。软针的柔软质地和钢针的牢固性,都能够在不同方面提高患者的舒适度,增强患者对治疗的接受度。
适应多样化治疗场景
这种设计能够适应不同患者在不同生活场景下的治疗需求。患者的生活场景多种多样,如工作、运动、睡眠等。在不同的生活场景下,患者对胰岛素泵的使用需求也不同。钢针适合在运动等场景下使用,而软针则适合在日常休息等场景下使用。这种多样化的耗材设计,使胰岛素治疗更加灵活有效,能够适应不同患者在不同生活场景下的治疗需求。
报警功能参数响应
防水级别响应
保障设备安全使用
胰岛素泵防水级别≥IPXXX8,能够有效防止水的侵入。在日常生活中,患者可能会遇到各种有水的环境,如洗手、洗澡等。高防水级别可以确保胰岛素泵在这些环境下正常工作,避免因水侵入而导致设备损坏。这保障了设备在正常使用过程中的安全性和稳定性,减少了因设备故障而影响治疗的可能性。
项目
详情
防水级别
≥IPXXX8
作用
防止水侵入,保障设备安全稳定
适应多种使用环境
高防水级别使胰岛素泵可以在多种环境下使用。患者在洗澡、游泳等情况下也无需担心设备损坏。这为患者的生活提供了更多的便利,使患者能够更加自由地参与各种活动。即使在潮湿的环境中,胰岛素泵也能正常工作,确保患者的胰岛素治疗不受影响。
延长设备使用寿命
防水设计能够减少因水侵入而导致的设备故障,延长胰岛素泵的使用寿命。水侵入可能会损坏设备的电子元件,导致设备故障。防水级别≥IPXXX8的设计,可以有效防止水的侵入,减少设备故障的发生。这不仅可以降低患者的使用成本,还可以确保患者在较长时间内使用稳定可靠的胰岛素泵。
项目
详情
设计特点
防水设计
作用
减少故障,延长设备使用寿命
提高患者使用信心
可靠的防水性能让患者更加放心地使用胰岛素泵。患者在使用胰岛素泵时,担心设备损坏会影响治疗效果。高防水级别可以消除患者的这种顾虑,提高患者对设备的信任度和使用信心。患者可以更加安心地进行日常活动,不用担心胰岛素泵因水的侵入而损坏,从而更好地配合治疗。
储药器状态显示响应
实时掌握剩余药量
胰岛素泵具备储药器状态显示功能,可显示剩余胰岛素的量从100%到1%。这使患者能够实时掌握胰岛素的剩余量,及时了解自己的治疗情况。患者可以根据显示的剩余药量,合理安排胰岛素的使用和储药器的更换时间。实时掌握剩余药量可以避免胰岛素短缺的情况发生,保障患者的治疗效果。
项目
详情
显示功能
显示剩余胰岛素量从100%到1%
作用
实时掌握药量,保障治疗效果
避免胰岛素短缺情况
患者可以根据显示的剩余药量及时准备更换储药器,
提升分级诊疗能力建设项目第一批.docx